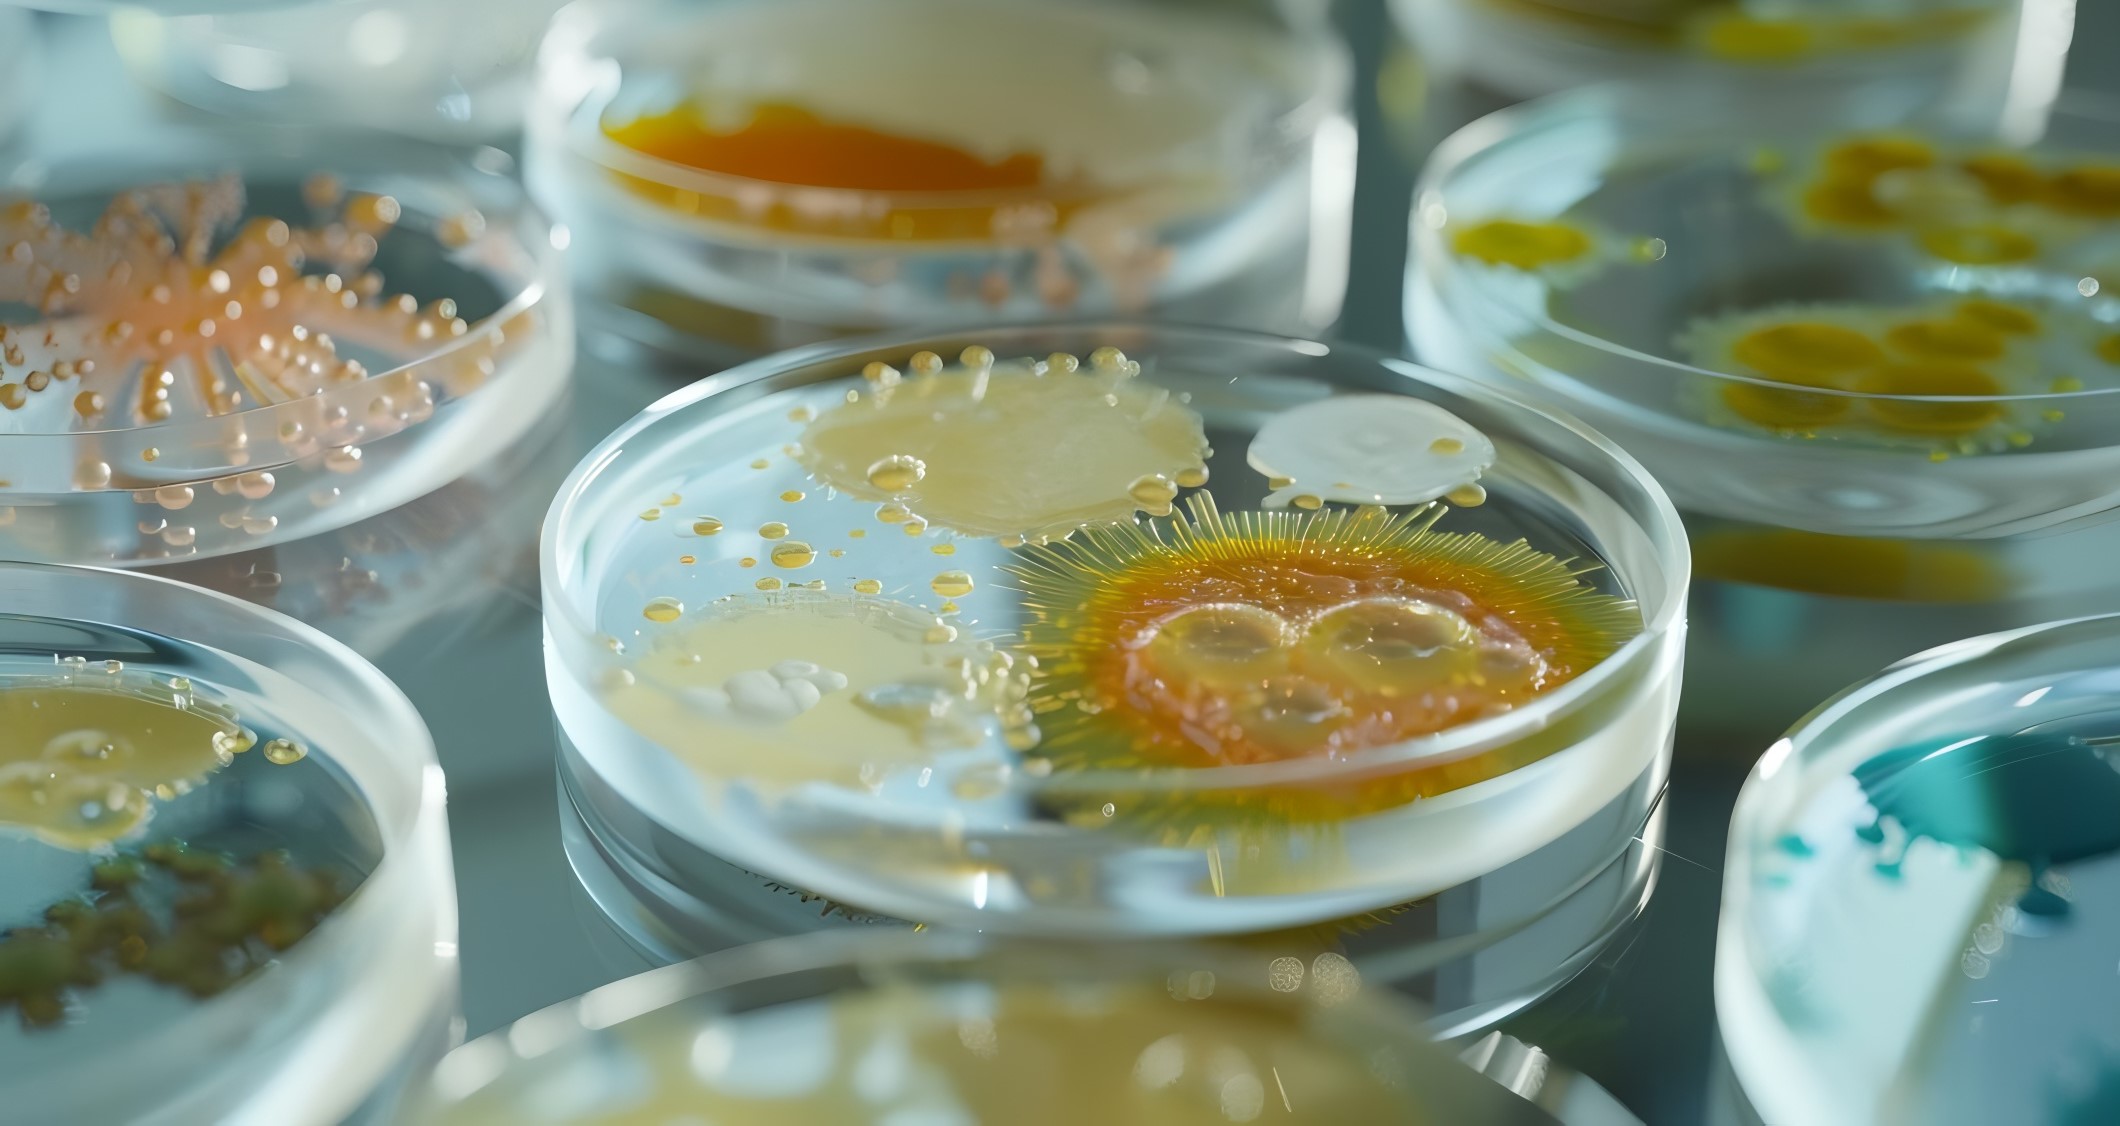

Sterilization in place fermentor for bioprocess applications
Optimize your fermentation processes with seamless integration of sterilization, sampling, and control, achieving precision and customization in microbial and cell culture production.

Facilitates Bioculture Sterilization and Harvesting
The MSJ and MPF Series from Marubishi Bioengineering are engineered-to-order fermentors tailored for diverse bioprocessing needs in the biotechnology and pharmaceutical industries. These fermentors are distinguished by their ability to perform sterilization in place using live steam, ensuring contamination-free operations for producing high-quality bioproducts such as monoclonal antibodies, recombinant proteins, and biofuels.
Available in sizes ranging from 10 to over 10,000 liters, these systems cater to both research and industrial-scale operations. They feature graphic touch panels and automated control systems, allowing seamless integration and streamlined operations including sterilization, sampling, and precise agitation. The fermentors accommodate various culture types—microbial, mammalian, and recombinant DNA—backed by Marubishi’s extensive experience.
Built with mechanical seal technology, these fermentors optimize energy usage and sterility. Offered with options for pH, DO, and airflow monitoring, they support a wide array of applications from R&D labs to large-scale production facilities. Marubishi provides comprehensive engineering support for custom configurations, ensuring compatibility with GMP standards and ease of maintenance with flexible cleaning systems.
Benefits
- Enhances operational efficiency with automated sterilization and sampling processes.
- Minimizes contamination risks with in-place sterilization using live steam.
- Accommodates scaling needs, from R&D to industrial production, with customizable vessel sizes.
- Reduces energy usage through variable-speed agitation and optimized control systems.
- Complies with stringent GMP standards, ensuring regulatory adherence and product safety.
- Applications
- Microbial cultures, Biofuels, Cell cultures, Nutraceuticals, Biopharmaceuticals, Enzymes, Dna recombinant
- End products
- Biodiesel, Vaccines, Bioethanol, Monoclonal antibodies, Liposomal supplements, Lactase enzyme, Amylase enzyme, Yogurts, Recombinant proteins, Protein therapeutics, Probiotics
- Steps before
- Seed culture preparation, Scaling down test, Determining culture conditions
- Steps after
- Sampling, Harvesting, Transfer to the next process
- Input ingredients
- seed culture, microbes, mammalian cells, DNA recombinant, cell mass
- Output ingredients
- protein, culture medium, harvested cells, processed biomass
- Market info
- Marubishi Bioengineering is known for its expertise in manufacturing high-quality bioreactors and fermentation systems for the biotechnology and pharmaceutical industries, reputed for their precision-engineering and customization to meet specific client requirements.
- Vessel Size
- 10, 20, 30, 50, 70, 90, 100, up to 10, 000+ Liters
- Sterilization Method
- Sterilization in place with live steam
- Agitation System
- Top or bottom entry driving
- Control Panel
- Graphic touch panel
- Automation
- Automated operating procedures
- Temperature Control
- Available
- Agitation Speed Control
- Available
- Optional Measurement/Control Items
- pH, DO, anti-foaming, air flow rate
- Mechanical Seal Technology
- For agitator shaft seal
- Automation level
- Manual / PLC
- CIP/SIP
- SIP with live steam
- Cleaning method
- SIP / Manual
- Batch vs. Continuous Operation
- Batch
- Integrated Steps
- Sterilization, Sampling, Harvesting, Transfer
- Fermentor vessel size
- 10, 20, 30, 50, 70, 90 L
- Fermentor vessel size
- 100 L to 10, 000 L
- Fermentor vessel size
- Custom sizes over 10, 000 L
- Agitation system entry point
- Top / Bottom
- Control panel type
- Graphic touch panel
- Fermentor vessel sizes
- 10, 20, 30, 50, 70, 90L
- Fermentor vessel sizes for large scale
- 100L to 10, 000L
- Agitation system
- Top or bottom entry driving
- Control items
- Temperature, agitation speed
- Optional measurement/control items
- pH, DO, anti-foaming, air flow rate
- Automation system
- Automated sterilization, sampling, harvesting
- System integration
- Hardware and software customizability
- Customized design and manufacturing
- Available for > 10 kilo liters
- Graphical touch panel
- For operation ease